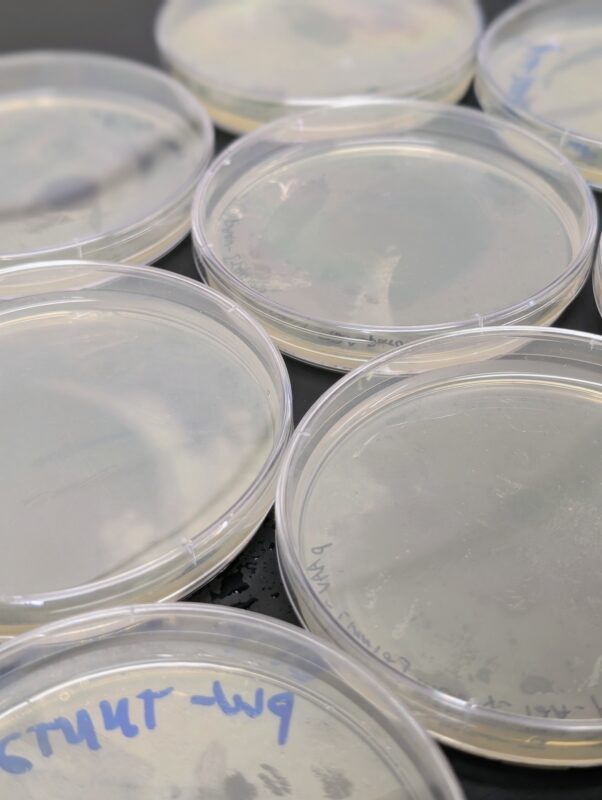

Genetically Engineered iPSCs
At Greenstone Biosciences, we bring together cutting-edge gene-editing technologies and human iPSC biology to create highly versatile, customizable research models. Using CRISPR/Cas9 and other advanced editing platforms, we can introduce precise genetic changes—ranging from knockouts and knock-ins to the integration of reporter constructs—in human induced pluripotent stem cells (iPSCs). These engineered cell lines provide powerful systems for studying gene function, understanding disease mechanisms, and exploring therapeutic strategies in a controlled and reproducible setting.
Precision Engineering for Deeper Insights
Our editing approach allows scientists to ask and answer fundamental questions about biology:
- What happens when a disease-associated gene is disrupted?
- How does a specific mutation alter cellular pathways?
- Can therapeutic interventions reverse or compensate for these effects?
By creating isogenic pairs of edited and unedited cells, we minimize experimental variability and provide direct comparisons that link genetic changes to cellular and functional outcomes. This ensures that researchers can confidently interpret results and accelerate the validation of potential drug targets.
A Platform to Accelerate Discovery
Engineered iPSC lines serve as an invaluable tool across the biomedical research spectrum:
Target validation
Confirm the role of candidate genes in disease pathways.
Mechanistic studies
Explore how specific mutations or pathways drive pathology.
Drug screening
Test therapeutic compounds in disease-relevant genetic contexts.
Cell therapy development
Engineer iPSCs to produce differentiated cells with desired traits or therapeutic potential.
By enabling researchers to establish a direct connection between genotype and phenotype, our platform transforms iPSCs into highly informative models that drive discovery from the bench to the clinic.
Expertise and Collaboration
Greenstone Biosciences not only provides gene-edited iPSCs but also offers collaborative support, helping researchers design the most effective editing strategies for their specific goals. Our team’s expertise in cell biology, gene editing, and translational medicine ensures that each project is guided by scientific rigor and tailored to advance therapeutic innovation.
Building the Future of Precision Medicine
With CRISPR-engineered iPSCs, Greenstone is helping to lay the foundation for precision medicine, where therapies are informed by the genetic and cellular underpinnings of disease. Whether you are studying rare genetic disorders, investigating complex diseases, or designing next-generation therapeutics, our platform provides the tools and expertise to move your ideas forward with confidence.
Engineer Your iPSC Models Today
Transform your research with custom-engineered iPSC lines designed for precision, reproducibility, and discovery.
